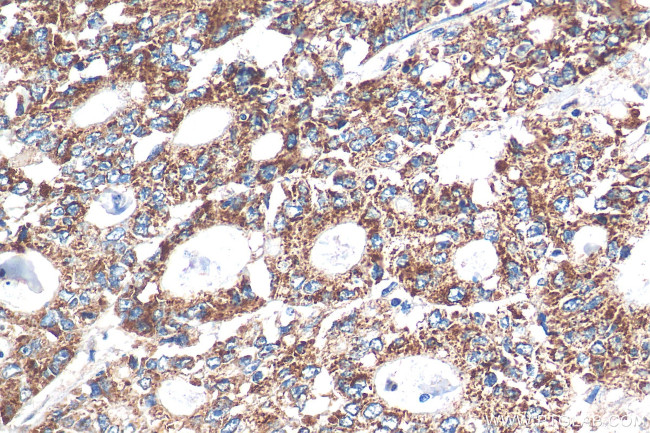
STEAP2 Antibody in Immunohistochemistry (Paraffin) (IHC (P))

Search
Proteintech
STEAP2 Polyclonal Antibody
{{$productOrderCtrl.translations['antibody.pdp.commerceCard.promotion.promotions']}}
{{$productOrderCtrl.translations['antibody.pdp.commerceCard.promotion.viewpromo']}}
{{$productOrderCtrl.translations['antibody.pdp.commerceCard.promotion.promocode']}}: {{promo.promoCode}} {{promo.promoTitle}} {{promo.promoDescription}}. {{$productOrderCtrl.translations['antibody.pdp.commerceCard.promotion.learnmore']}}
产品信息
24804-1-AP
种属反应
宿主/亚型
分类
类型
抗原
偶联物
形式
浓度
规格
纯化类型
保存液
内含物
保存条件
运输条件
产品详细信息
Immunogen sequence: QLGPKDASRQ VYICSNNIQA RQQVIELARQ LNFIPIDLGS LSSAREIENL PLRLFTLWRG PVVVAISLAT FFFLYSFVRD VIHPYARNQQ SDFYKIPIEI VNKTLPIVAI T
靶标信息
The six-transmembrane epithelial antigen of prostate 2 (STEAP2) is a member of a family of metalloreductases identified as cell-surface antigens in prostate tissue. Similar to two other members of the STEAP family (STEAP 3 and STEAP4), STEAP2 promotes both iron and copper reduction. STEAP2 expression in transfected cells also correlated with iron or copper uptake, suggesting that the STEAP family of proteins may function to stimulate iron and copper uptake. STEAP2 is widely expressed in many tissues in the plasma membrane, but is most highly expressed in prostate. At least three isoforms of STEAP2 are known to exist.
仅用于科研。不用于诊断过程。未经明确授权不得转售。
篇参考文献 (0)
生物信息学
蛋白别名: Metalloreductase STEAP2; Prostate cancer-associated protein 1; Protein up-regulated in metastatic prostate cancer; protein upregulated in metastatic prostate cancer; PUMPCn; six transmembrane epithelial antigen of the prostate 2; Six-transmembrane epithelial antigen of prostate 2; SixTransMembrane Protein of Prostate 1; STEAP family member 2, metalloreductase; STMP v1; STMP v2; unnamed protein product
基因别名: IPCA1; PCANAP1; PUMPCn; STAMP1; STEAP2; STMP; UNQ6507/PRO23203
UniProt ID: (Human) Q8NFT2
Entrez Gene ID: (Human) 261729